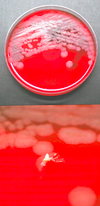

Bacteriology Flashcards
(182 cards)
Sites that should not be cultured for anaerobes
stool
skin
vagina
urethra
oropharynx
Characteristics of blood culture
Each bottle has 10 ml blood (adults)
2 bottle set (1 aerobic and 1 anaerobic) collected from one site
multiple sets obtained from multiple sites: need 3 sets
Cell wall in gram + and - organisms
- Gram positive: thick peptidoglycan cell wall without outer membrane; retains purple crystal violet/iodine stain during decolorization
- Gram negative: thin peptidoglycan cell wall with outer membrane; lose crystal violet/iodine during decolorization and are visualized with the red safranin stain
Appearance of the following organisms on gram stain
- Strep pyogenes
- Nonpyogenic strep
- Strep pneumoniae
- Enterococcus species
- Neisseria
- vibrio
- campylobacter
- yersinia
- legionella
Gram positive cocci:
- pairs and short chains
- long chains
- lancet shaped diplococci
- diplococci
Gram negative cocci
Neisseria - coffee bean shaped diplococci
Gram negative rods
- curved, comma shaped, short
- curved, thin (seagulls or corkscrew)
- closed safety pin
- invisible in primary smear
Pleomorphic gram positive rods
- Aerobic
- Aerotolerant
- Anaerobic, nonspore forming
- Aerobic
- Corynebacterium
- Other coryneforms (e.g., Rothia, arthrobacter)
- Non-nocardia actinomycetes
- Aerotolerant
- Actinomyces
- Bifidobacterium
- Anaerobic, nonspore forming
- Propionibacterium
Small to medium gram positive rods
- Aerobic
- Aerotolerant
- Anaerobic, nonspore forming
- Anaerobic, spore forming
- Aerobic
- Listeria
- Erysipelothrix
- Aerotolerant
- Lactobacillus strains
- Anaerobic, non spore forming
- Eubacterium
- Lactobacillus
- Anaerobic, spore forming
- Clostridium ramosum
Large gram positive rods
- Aerobic
- Anaerobic, nonspore forming
- Anaerobic, spore forming
- Aerobic
- Bacillus
- Anaerobic, nonspore forming
- Clostridium perfringens
- Anaerobic, spore forming
- Other clostridia
Branching, filamentous aerobic and anaerobic nonspore forming gram positive rods
Aerobic:
Nocardia
Anaerobic, nonspore forming:
Actinomyces israelii
Acid Fast Stains
Mycobateria:
- cell wall structure of gram positive bacteria but contain mycolic acids, which repel crystal violet/iodine; thus are usually gram invisible
- dye penetrates hydrophobic barrier to stain mycolic acids in cell wall
- Ziehl-Neelsen: red carbol fuschin dye containing phenol is heated so it can penetrate cell wall; strong acid (3% HCl) decolorizes
- Kinyoun (cold technique): higher concentration of phenol and no heat; otherwise same as ZN
-
Fite (modified) acid-fast: weaker decolorizing reagent; good for:
- nocardia
- cryptosporidium
- isospora
- cyclospora
- sarcocystis
- legionella
Alternative stain for acid fast bacilli
Fluorescent auramine rhodamine stain
Buffered charcoal yeast agar
Legionella grows because media has cysteine and iron
Thioglycolate broth
Cultivation of bacteria, including microaerophilic and obligately anaerobic bacteria; oxygen tension decreases at bottom of tube, allowing for growth of anaerobes
MAC agar
- bile salts and crystal violet inhibit growth of Gram+ bacteria and allow for growth of Gram-
- Lactose fermentation results in pink color
Eosin methylene blue agar
- aniline dyes inhibit growth of gram+ bacteria and allow for growth of gram negative rods
- lactose fermentation results in purple-black colonies with a green metalic sheen
- differentiates lactose fermenting and non-fermenting enterics
campylobacter blood agar
contains cephalothin, vanc, trimethoprim, amphotericin B, polymyxin B
allows for recovery of campylobacter
Hektoen enteric agar
- Bile salts and the dyes bromthymol blue and acid fuchsin inhibit Gram+ and some Gram- strains
- recover salmonella and shigella better than MAC
- lactose and/or sucrose fermentation results in yellow or orange color, otherwise translucent
- H2S production results in black coloration
Selenite broth
Sodium selenite inhibits growth of gram+ bacteria and many enterics other than salmonella
- allows for enrichment of salmonella
Thiosulfate citrate bile salts sucrose agar (TCBS)
- Bile salts inhibit gram+ bacteria
- Alkaline pH inhibits most enterics and enhances growth of vibrio species
- sucrose fermentation results in yellow colonies
- differentiated between sucrose fermenting vibrio (e.g., V cholerae) and nonfermenters (other vibrio)
Cefsulodin-Irgasan-novobiocin (CIN) agar
- antimicrobial and crystal violet inhibit most gram negative bacteria other than yersinia
- recover yersinia
- mannitol fermentation results in bull’s eye colonies (colorless with red center), otherwise translucent
- differentiates between manitol fermenters (yersinia enterocolitica) and nonfermenters (other yersinia)
Anaerobic colistin nalidixic acid (CNA) agar
- antimicrobials inhibit gram negative bacteria
- recover anaerobic streptococci; blood in agar allows differentiation based on hemolytic reactions
Lim broth
antimicrobials inhibit gram negative bacteria
- recovers Group B streptococci (agalactiae)
Regan-Low medium
contains antimicrobials that allow for selective growth of Bordetella pertussis and bordetella parapertussis
Thayer-martin medium
Allows for growth of Neisseria
Vanc, colistin, nystatin, and SXT block growth of orgs
Salmonella-shigella agar
- Lactose fermentation results in pink or red colonies
- H2S production makes black color
- good for enterics